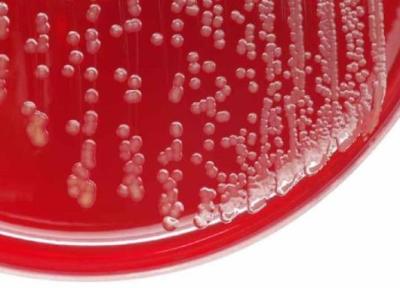

آخرین ارسال ها در وبلاگ های مجله هاستفا | صفحه 89

نوزدهمین شماره ماهنامه میراث در قرقیزستان منتشر شد
به گزارش خبرنگاران به نقل از روابط عمومی سازمان فرهنگ و ارتباطات اسلامی، در این شماره از میراث که در 46 صفحه تهیه شده، مطالبی با عناوین ایران در ششمین جشنواره بین المللی حماسه های ملل دنیا در بیشکک، بخارای شریف و رسالت بیدارگری مسلمانان سیدعلی مزینانی...

مشخصات نو گوشی های مجذوب کننده سری Reno7 اوپو
تقریباً چند هفته پیش بود که گزارشی درباره یکی از گوشی های سری آینده Reno7 اوپو منتشر شد که برخی مشخصات اصلی آن را افشا می کرد، اما اکنون یک گزارش نو نشان می دهد که این سری شامل سه گوشی Reno7، Reno7 Pro و Reno7 SE است و مشخصات اصلی آن ها را نیز در بر دارد.

عجیب و غریب ترین مانتو در تن ترلان پروانه!
خبرنگاران: ترلان پروانه اخیرا عکسی جدیدی را با استایل عجیبش در فضای مجازی منتشر کرد.

آتش دوباره به دکه ها رسید
به گزارش خبرنگاران؛ دومین شماره از ماهنامه ادبی- هنری آتش با مدیر مسئولی محمد عسلی و سردبیری عبدالرحمان مجاهدنقی به چاپ رسید.

متا (فیسبوک سابق) اپل را با ساعت هوشمند دوربین دار به چالش می کشد
پیش تر خبر هایی منتشر شدند که نشان می دادند شرکت فیسبوک نام خود را به متا تغییر داده است. اما با وجود اینکه هنوز جوهر بیانیه منتشر شده از طریق مارک زاکربرگ خشک نشده بود، نشریه بلومبرگ تصویری را از یک ساعت هوشمند مجهز به دوربین جلویی منتشر کرد.

فواید و خواص آویشن در سلامتی ومضرات آن
آویشن گیاهی است از خانواده نعناع که احتمالاً شما از آن به عنوان ادویه استفاده می کنید. اما آویشن بسیار بیشتر از یک ادویه است. دامنه استفاده از آویشن چشمگیر است و بیش از 400 زیرگونه دارد. آویشن به علت طعم و مزه متمایز ، تا به امروز جزء اصلی آشپزی ها بوده...

جاده کلی، اوهایوویل، پنسیلوانیا
در فاصله یک مایلی جاده ی کلی در اوهایوویل پنسیلوانیا، منطقه یی وجود دارد که اخبار بی شماری حاوی فعالیت های ماورایی و اتفاقات عجیب از آن جا گزارش شده است. گزارش ها حاکی از آن است که وقتی حیوانات وارد این منطقه تسخیر شده می شوند آرامش خود را از دست می...

ایران برای حضور زنان در استادیوم تعهد داده است
داریوش مصطفوی، رییس کمیته استیناف صدور مجوز حرفه ای فدراسیون فوتبال پس از جلسه امروز (چهارشنبه) مدیران باشگاه ها با مدیران سازمان لیگ و فدراسیون فوتبال اظهار کرد: جلسه ابعاد مختلفی داشت. هدف جلسه روی تبلیغات محیطی و صدا و سیما بود که عایدی برای فدراسیون...

شیشه های بازیافتی را تزئین کنید
خبرنگاران : تزئین شیشه های بازیافتی هنری است که به خلاقیت نیاز دارد.

8 استان بارانی هستند؛ کاهش 12 درجه ای دمای نیمه شمالی کشور
تهران (پانا) - طبق اعلام سازمان هواشناسی بارش باران در هشت استان طی امروز 11 آبان ادامه دارد.

آشنایی با خواص فوق العاده فلفل قرمز
تسکین درد، کاهش وزن، برطرف سردی، سلامت پروستات مردان و جلوگیری از انواع سرطان از خواص فلفل قرمز است. در این مقاله به آنالیز خواص فلفل قرمز می پردازیم.

نگاهی به کاربرد پزشکی درخت ارکیده (بهیمه)
ریشه این گیاه با آب سائیده می گردد و برای تب سرماخوردگی، نوشیده می گردد. گل ها به عنوان ملین و برگ ها برای جراحت و کورک و بعلاوه درمان سرفه به کار می رود.

ویسی: یک تیم گردن کلفت را شکست دادیم ، می خواهم شریک تیم خوب باشم
خبرنگاران/خوزستان سرمربی تیم فوتبال فولاد خوزستان گفت: خدا را شکر توانستیم یک تیم بسیار گردن کلفت را که واقعا از آن می ترسیدیم، شکست دهیم.

راهنمای کامل نگهداری و تکثیر گیاه فیکوس بنجامین در خانه
فیکوس بنجامین یا انجیر برگ ریز یکی از گیاهان آپارتمانی زیبا و بومی منطقه ها استوایی و نیمه استوایی است. اگر دوست دارید در خانه یک درختچه زیبا داشته باشید، بنجامین گزینه مناسبی است. در ادامه در خصوص روش های نگهداری و مراقبت از بنجامین بیشتر بخوانید.

تصویر لپ تاپ 17 اینچی لنوو با دو نمایشگر فاش شد
ایوان بلاس، افشاگر دستگاه های الکترونیکی تصاویری از تینک بوک پلاس 17 اینچی لنوو منتشر کرده که نشان می دهد دستگاه یک نمایشگر ثانویه دارد.

جرم گوش چیست و روش های تمیز کردن جرم گوش بدون آسیب رساندن
جرم گوش حاصل از فرآیند دفاع گوش در برابر ورود میکروب ها و عوامل خارجی به داخل کانال گوش است. ماده زردرنگ جرم گوش نه تنها مضر نیست بلکه اثر محافظتی دارد. البته با این شرط که مقدار آن از حد نصاب بیشتر نشود.
عفونت استاف چیست؟
فونت های استاف عفونت ناشی از باکتری استافیلوکوک است، این باکتری نوعی میکروب است که معمولا در پوست یا بینی افراد، حتی افراد سالم یافت می گردد. بیشتر اوقات این باکتری مسئله ای ایجاد نمی کند و یا منجر به عفونت های پوستی نسبتا خفیف می گردد.

دیوار چین ایرانی را در گرگان ببینید! مار سرخ دومین دیوار طولانی آسیا
دیوار بزرگ باستانی گرگان که در استان گلستان واقع شده، به عنوان طولانی ترین اثر معماری ایران باستان و دومین دیوار تاریخی بلند در قاره آسیا پس از دیوار چین (به طول 6 هزار کیلومتر) با 200 کیلومتر طول از ساحل دریای خزر واقع در شمال گمیشان آغاز و بعد از طی راستا...

7 روش برای حذف دستگاه های بلوتوثی دردسرساز در ویندوز
هنگامی که قصد دارید از شر کابل های متعدد روی میز خود خلاص شوید، برترین گزینه برای شما استفاده از اتصال بلوتوث است. به سادگی و با انجام چند تنظیم ساده شما دستگاه بلوتوثی خود را به ویندوز وصل خواهید کرد. با این حال ممکن است که گاهی اوقات در قطع کردن این اتصال...

ریشه گل نیلوفر آبی و فواید آن
مزایای سلامت ریشه نیلوفر آبی می تواند به ترکیب منحصر به فرد آن از ویتامین ها، مواد معدنی و مواد مغذی شامل پتاسیم، فسفر، مس، آهن و منگنز و بعلاوه تیامین، پانتوتنیک اسید، روی، ویتامین B6 و ویتامین C مربوط باشد.